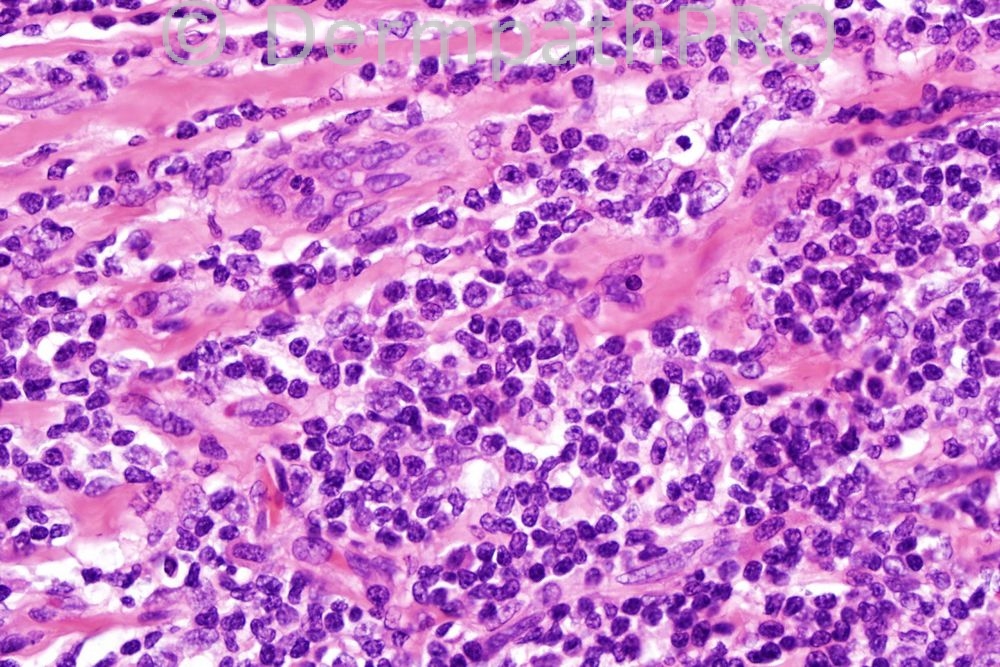

Case Number : Case 422 Posted By: Guest
Please read the clinical history and view the images by clicking on them before you proffer your diagnosis.
Submitted Date :
Female 43 years, slowly growing purple nodule on trunk.

User Feedback